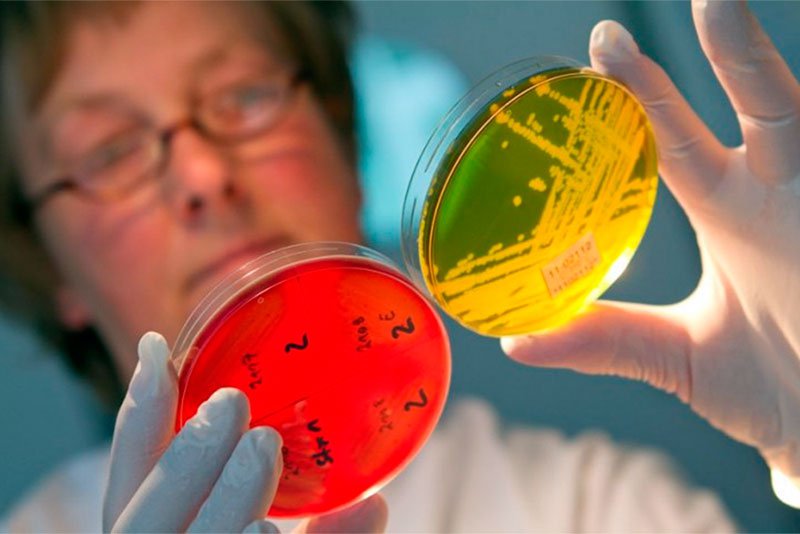
Протейная инфекция

Протей (Proteus) – это условно-патогенный обитатель кишечника человека и животных, который может длительное время существовать в воде и почве. Довольно долго этому микроорганизму не придавали большого значения в развитии инфекционно-воспалительных заболеваний. Но в последнее время в связи с усовершенствованием диагностики роль протея как возбудителя серьезных недугов подтверждается все чаще. При этом зачастую он становится причиной нозокомиальных (госпитальных – связанных с пребыванием в медицинском учреждении) инфекционных заболеваний, которые тяжело поддаются лечению.
Протейная инфекция: пути заражения
Источниками протейной инфекции являются больные люди и животные, с калом которых патогенные микроорганизмы в больших количествах попадают в окружающую среду. Далее протей может проникнуть в организм человека следующими путями:
- С пищей, обсемененной возбудителем (преимущественно с подпорченными мясными и молочными продуктами, рыбой, немытыми овощами и фруктами и т.д.).
- Через воду (при купании и заглатывании воды).
- Через грязные руки, посуду, предметы быта.
Отдельно стоит выделить особенности инфицирования протеем в медицинских учреждениях. Передача данной инфекции в них происходит преимущественно через инструменты, которыми пользуются врачи и медсестры во время лечебных манипуляций, а также предметы ухода за больными. Вследствие такого заражения развивается раневая инфекция, пиелонефрит (воспаление чашек и лоханок почки), воспаление пупка у новорожденного, отиты, синуситы и т.п.
Факторы, способствующие развитию воспалительных процессов при заражении протеем, следующие:
- бесконтрольный прием антибиотиков;
- ослабление защитных сил организма вследствие хронических заболеваний, иммунодефицитов, патологий крови, физиологической незрелости иммунной системы у новорожденных деток и малышей до года, а также возрастного истощения иммунитета у стариков.
Врачи отмечают, что протейная инфекция, вызванная бактериями рода Proteus, может проявляться различными симптомами, включая лихорадку, боли в животе, а также нарушения мочеиспускания. Часто пациенты жалуются на неприятный запах мочи и мутную жидкость, что может указывать на наличие инфекции мочевыводящих путей. Лечение обычно включает антибиотики, однако выбор препарата зависит от чувствительности бактерий, что требует предварительного лабораторного анализа. Врачи подчеркивают важность профилактики, включая соблюдение личной гигиены, достаточное потребление жидкости и своевременное лечение заболеваний, способствующих развитию инфекций. Регулярные медицинские осмотры также помогают выявить потенциальные проблемы на ранних стадиях.

Как развивается протейная инфекция?
У здоровых людей данный микроорганизм может длительное время находиться в нижних отделах пищеварительного тракта без каких-либо патологических признаков. Однако нарушение нормальной кишечной микрофлоры в сторону уменьшения в ней количества кишечных палочек, бифидо и лактобактерий становится идеальной почвой для активации таких микробов, как протей. Развивающееся в подобных ситуациях состояние называют дисбактериозом кишечника. Если же человек «съест» большое количества протеев вместе с некачественными продуктами или водой, у него с высокой вероятностью возникнут симптомы острого гастроэнтерита.
Когда же протей проникает из внешней среды в те места организма человека, где в норме этой бактерии быть не должно, развиваются гнойно-воспалительные заболевания. Локализация таких воспалительных процессов может быть любой – мочеполовые органы, раны, ухо, околоносовые синусы и т.д.
Протей: симптомы заболеваний
Инкубационный период при заболеваниях, вызванных протеем, обычно длится от нескольких часов до 2-3 дней. Специфических симптомов, характерных имен для этой инфекции, нет. Например, при поражении протеем желудочно-кишечного тракта у больных появляются признаки, присущие и другим острым инфекционным недугам ЖКТ:
- повышенная температура;
- слабость, головная боль и другие проявления интоксикации (протей синтезирует эндотоксин);
- тошнота и рвота;
- расстройства стула (кал становится жидким и зловонным, дефекация повторяется 4-5 раз в сутки);
- схваткообразные непостоянные боли в животе;
- урчание в кишечнике и метеоризм.
Если поражаются мочевыделительные пути, появляется боль при мочеиспускании (при цистите, уретрите), интоксикация, повышается температура тела, а в моче выявляются лабораторные признаки воспалительного процесса. При раневой протейной инфекции раны гноятся и плохо заживают.
Протейная инфекция вызывает много обсуждений среди пациентов и медицинских специалистов. Люди отмечают, что симптомы могут варьироваться от легкого дискомфорта до серьезных проявлений, таких как высокая температура, боли в животе и нарушения мочеиспускания. Часто пациенты жалуются на затруднения в диагностике, так как симптомы могут быть схожи с другими заболеваниями. Лечение, как правило, включает антибиотики, но многие отмечают, что устойчивость к препаратам делает терапию сложной. Профилактика инфекции включает соблюдение гигиенических норм и своевременное лечение сопутствующих заболеваний. Важно также следить за состоянием здоровья и обращаться к врачу при первых признаках недомогания.

Протей у детей
Протейная инфекция особенно опасна для новорожденных, которые могут столкнуться с ней в лечебных учреждениях (роддоме, неонатальных отделениях). Вследствие заражения у малышей развивается выраженный токсикоз, рвота, диарея и сильное обезвоживание. Кроме того, высока вероятность инфицирования протеем пупочной ранки и возникновения омфалита. Такое воспаление очень быстро распространяется на пупочную и портальную вены, что чревато сепсисом. Помимо этого, заражение протеем новорожденных может привести к развитию у них острого гнойного менингита.
У более взрослых детей протейная инфекция чаще всего проявляется симптомами поражения ЖКТ, мочевыводящих путей, уха, околоносовых синусов, легких, а также гнойно-воспалительными процессами на коже.
Диагностика
Первичная диагностика заболеваний, вызванных протеем, основывается на клинической картине и выявлении наличия факторов риска у больного. Главный же и наиболее достоверный метод диагностики протейной инфекции – бактериологический, то есть посев материала, взятого от больного, на питательные среды и выделение возбудителя. Исследуемым материалом может быть кал, моча, отделяемое ран, ушные выделения – все зависит от формы инфекции.
Помимо этого, определенное значение имеют и серологические анализы на протей, однако их результат пригоден больше не для выявления, а для ретроспективного подтверждения наличия инфекции, поскольку окончательные данные врач может получить только через 2 недели после первичного анализа. К этому времени больной уже может быть здоровым.

Лечение протейной инфекции
Для лечения протейной инфекции в большинстве случаев применяют антибиотики. Причем для действительно эффективной антибактериальной терапии необходимо сделать антибиотикограмму – анализ на чувствительность возбудителя к различным антибактериальным препаратам. Это исследование имеет особенное значение в случае госпитальных заболеваний, поскольку протеи, взывающие их, практически всегда нечувствительны ко многим антибиотиком, поэтому стандартное лечение может оказаться не достаточно результативным. Таким больным антибактериальные препараты для лечения протея обычно назначают не по одному, а комбинируют по несколько, чтобы полностью уничтожить возбудителя.
Помимо этого, при протейной инфекции широко применяются бактериофаги (препараты, содержащие вирусы бактерий). Особенно часто их назначают при дисбактериозе и избыточном росте протея на посевах кала маленьких детей.
Еще одним важным моментом лечения протейной инфекции является восстановление нормальной микрофлоры кишечника. Для этого используют специальные бактериальные препараты и пребиотики (лекарства, содержащие вещества, обеспечивающие хорошее размножение в кишечнике «полезных» микроорганизмов).
У больных с протейной инфекцией на фоне ослабленного иммунитета могут применяться иммуномодулирующие средства и аутовакцины (иммунологические препараты, созданные на основе патогенной бактерии, выделенной от больного).
Симптоматическое лечение при заболеваниях, вызванных протеем, назначается в зависимости от наличия конкретных признаков. При необходимости проводится дезинтоксикационная терапия, регидратация, применяются энтеросорбенты, жаропонижающие средства и т.д.
Профилактика
В быту человек может предупредить заражение протеем следующим образом:
- Соблюдая базовые гигиенические правила.
- Употребляя качественные продукты, прошедшие достаточную термическую обработку, а также безопасную воду.
- Поддерживая чистоту в доме.
Профилактика же протейной инфекции в медицинских учреждениях – это уже задание медицинских работников. Причем важно, чтобы в больницах не только соблюдались санитарно-гигиенические правила (качественная дезинфекция, стерилизация, разделение «чистых» и «гнойных» больных и т.п.), но и сводились к минимуму любые инвазивные манипуляции, во время которых в большинстве случаев и происходит инфицирование.
Что касается профилактики активации «своего родного» протея в кишечнике, то главное, что необходимо помнить, – это никакого самолечения антибиотиками. Именно эти препараты при неумелом применении чаще всего провоцируют развитие серьезного дисбактериоза.
Зубкова Ольга Сергеевна, медицинский обозреватель, врач-эпидемиолог
Вопрос-ответ
Чем лечить Proteus vulgaris?
Для лечения заболеваний, вызванных P. Vulgaris используются левомицетин, мономицин и стрептомицин. Профилактика включает проведение обще санитарных мероприятий, соблюдение санитарного режима в детских учреждениях и стационарах.
Что такое протейная инфекция?
Протейная инфекция — энтеробактериальная болезнь молодняка животных, в том числе птиц, характеризующаяся нарушением пищеварения. Возбудитель. Болезнь вызывают кишечные бактерии из семейства Enterobacteriaceae.
Какой препарат убивает Proteus mirabilis?
Большинство изолятов P. Mirabilis восприимчивы к ампициллину, таким образом, это соединение обычно является основой лечения. Для инвазивных инфекций, таких как пневмония или менингит, часто используется эмпирическая комбинированная терапия с аминогликозидом .
К какому антибиотику устойчив Proteus vulgaris?
Vulgaris обладают естественной устойчивостью к полимиксинам (колистину), нитрофуранам, тигециклину и тетрациклину . P. Vulgaris чувствительны к антибиотикам, таким как ампициллин и ципрофлоксацин. См. Протокол USC по оценке и наблюдению после воздействия. Использование острых предметов должно быть строго ограничено.
Советы
СОВЕТ №1
Регулярно следите за состоянием своего здоровья и обращайте внимание на любые необычные симптомы, такие как покраснение, отек или болезненность в области кожи. Раннее выявление протейной инфекции может значительно упростить лечение и предотвратить осложнения.
СОВЕТ №2
При наличии хронических заболеваний или ослабленной иммунной системы обязательно консультируйтесь с врачом о необходимости профилактических мер. Это может включать вакцинацию или прием иммуномодулирующих препаратов.
СОВЕТ №3
Соблюдайте правила личной гигиены, особенно если вы работаете в медицинской сфере или ухаживаете за больными. Регулярное мытье рук и использование антисептиков помогут снизить риск заражения протейной инфекцией.
СОВЕТ №4
Если вы уже столкнулись с симптомами протейной инфекции, не занимайтесь самолечением. Обратитесь к врачу для получения точного диагноза и назначения адекватного лечения, которое может включать антибиотики и другие медикаменты.